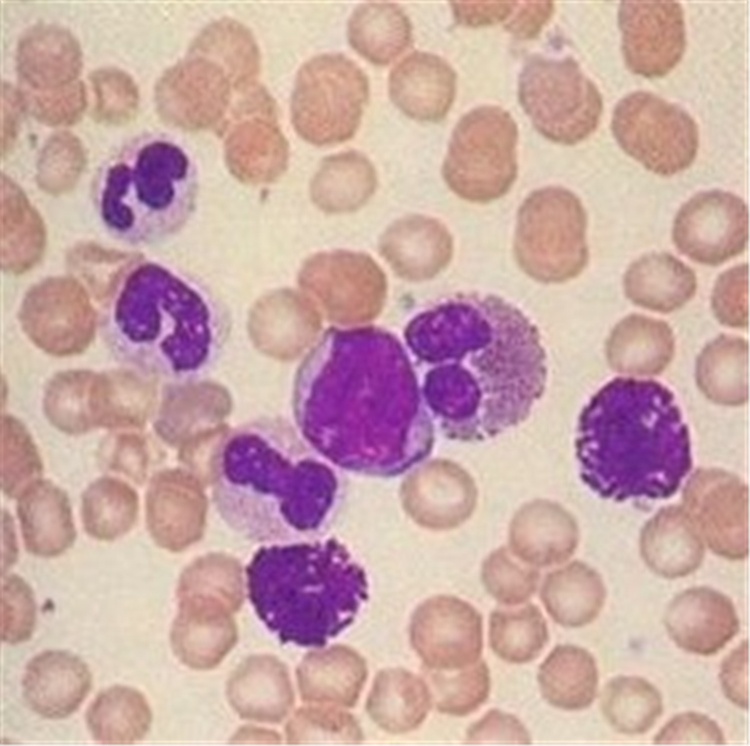

Other Teaching Resources
Найдено товаров - 1065

Образец жука из прозрачной эпоксидной смолы, таксидермия, принадлежности для школьной рукоделия, учебные материалы, другие учебные материалы
- Производитель (Поставщик): Nanning Benji Biological Technology Co., Ltd.
$1.98*
На складе

Другие Обучающие ресурсы, медицинские научные анатомические предметы для микроскопа, Наборы Слайдов для образовательных целей
- Производитель (Поставщик): Henan Yulin Edu. Project Co., Ltd.
$607.0*
На складе

Образец насекомых из смолы, с завода-поставщика
- Производитель (Поставщик): Nanning Titigood Education Technology Co., Ltd.
$2.30*
На складе
Студенческие предметы для студенческого микроскопа
- Производитель (Поставщик): Henan Green Medical Tech Co., Ltd.
$0.90*
На складе

Микроскоп Учебные ресурсы 100 шт. патология человека слайды для образования
- Производитель (Поставщик): CENCE MEDIKAL VE TICARET LIMITED SIRKETI
$200.00*
На складе

Учебные ресурсы, фиксированный набор 100 видов тканей и насекомых для животных, микроскопы, подготовленные слайды
- Производитель (Поставщик): Xinxiang Hongye Edu. Instrument Co., Ltd.
$30.00*
На складе

Обучающие ресурсы Медицинский эстетический Полный косметический кожный наполнитель для лица инъекционная Модель со скелетом внутри
- Производитель (Поставщик): Guangzhou Jianpu Healthcare Products Ltd.
$46.78*
На складе

Дидактический образовательный набор для тестирования почвы Учебные ресурсы для студентов
- Производитель (Поставщик): RAPITECH INSTRUMENTS LTD.
$5.00*
На складе

2022 полный набор инструментов для обучения физике для студентов
- Производитель (Поставщик): Jiangsu Zhaosheng Education Technology Co., Ltd.
$39.90*
На складе

Стоматологическая модель черепа для взрослых, анатомическая модель настоящего размера, Съемная 3D анатомическая модель человеческого черепа, модель черепа, мускулярная модель
- Производитель (Поставщик): Shenzhen Chuangxiang Artificial Intelligence Technology Co., Ltd.
",*
На складе

Распродажа, большие игровые деньги для детей, магнитные Обучающие ресурсы для обучения деньгам и монетам
- Производитель (Поставщик): Wenzhou Xiangtong Magnetic Technology Co., Ltd.
$19.90*
На складе

Биологические микроскопы, слайды, подарок для учеников средней школы, обучающий ресурс, 20 шт., набор зоологических слайдов
- Производитель (Поставщик): Ningbo Kingstic Trading & Industrial Co., Ltd.
$3.15*
На складе

Учебные ресурсы и учебное оборудование, школьное и медицинское оборудование, лидер продаж, слайды для микроскопа с хромосомой человека
- Производитель (Поставщик): Xinxiang Red Forest Edu. Instrument Co., Ltd.
$4.30*
На складе

Лидер продаж, 4 вида растений, акриловая смола для голосеменных образцов, обучающий ресурс для средней школы
- Производитель (Поставщик): Nanning Qianhui Education Technology Co., Ltd.
$72.50*
На складе

Биологический ПВХ 3D модель человеческого уха гигантское анатомическое ухо для медицинского образования в 3 раза увеличенное пластиковое ухо обучающий ресурс
- Производитель (Поставщик): M/S SCIENTIFIC AND SURGICALS
$11.80*
На складе

Часть продукта обучающих ресурсов мотора центрифуги
- Производитель (Поставщик): Xinxiang Vic Science & Education Co., Ltd.
$20.00*
На складе

Фабричные Медицинские Учебные ресурсы, учебное оборудование, университетские наборы зоологических слайдов, стеклянные слайды на заказ
- Производитель (Поставщик): Henan Yulin Edu. Project Co., Ltd.
$8480.12*
На складе

Деревянная настенная диаграмма роста для детей тканевая холщовая линейка для обучения детей
- Производитель (Поставщик): Honswill International Corporation
$0.45*
На складе

Медицинский учебный ресурс анатомическая модель плечевой ключицы и связки для медицинской науки
- Производитель (Поставщик): Xinxiang Alpha Manufacturing Ltd.
$2.50*
На складе

Образец из натурального хрусталя
- Производитель (Поставщик): Glamon Industry (shenzhen) Co., Ltd.
$8.50*
На складе

Модель кровососа для биологической анатомии учебно-экспериментальный ресурс для образования
- Производитель (Поставщик): Yongkang City Zhongzheng Teaching Instrument Co., Ltd.
$1.90*
На складе

Заводская оптовая продажа, 100 г-1000 г, поднос с весом, обучающий ресурс для студентов-физиков
- Производитель (Поставщик): Nanyang Zhidian International Trade Co., Ltd.
$7.80*
На складе

Пластиковый обучающий ресурс для анатомии человека в медицинской науке, 28 зубов
- Производитель (Поставщик): Suzhou Medical Teaching Model Co., Ltd.
$5.99*
На складе

Настоящая сушеная бабочка из прозрачной смолы, реалистичный учебный ресурс для младших классов средней школы, наблюдайте за образцами искусственного янтаря
- Производитель (Поставщик): Nanning Ambor Arts And Crafts Co., Ltd.
$8.90*
На складе

Обучающие ресурсы, подарок, 35 различных образцов, микроскоп, готовые слайды для детей, Обучающие
- Производитель (Поставщик): Henan Zhizao Teaching Instrument Co., Ltd.
$2.50*
На складе

Материалы тигра Монтессори: геометрический шкаф, сенсорные учебные пособия
- Производитель (Поставщик): Yunhe Xinqiao Toys Factory
$6.58*
На складе

Цифровой простой Водонепроницаемый Секундомер
- Производитель (Поставщик): Sichuan Machinery Tools Import & Export Co., Ltd.
$111.05*
На складе

Набор материалов для обучения физике, набор материалов для измерения плотности образцов из металлического блока
- Производитель (Поставщик): Wenzhou Lianying Education And Technology Co., Ltd.
$3.57*
На складе

Durable Silicon Skin Suture Practice Kit 3 Layer Suture Pad for Student Teaching Resources and Training Practice
- Производитель (Поставщик): DADDY D PRO
$1.00*
На складе

DIY восемь планет стволовых пластиковых извержений вулкана Метеостанция модель детского сада Учебные ресурсы наборы научных экспериментов
- Производитель (Поставщик): Guangzhou Sinosource Scientific Company Limited
$3.00*
На складе

Учебные ресурсы медицинская паразитология подготовила слайды для студентов, обучающих врачей, исследовательские стандартные слайды для Protozoa
- Производитель (Поставщик): Xinxiang Vic Science & Education Co., Ltd.
$237.45*
На складе

Учебные материалы для детей дошкольного возраста, фетровые рассказы, игровые наборы, складные фетровые фланелевые доски, Тихая книга для детей
- Производитель (Поставщик): Qingdao Sanhao Crafts Co., Ltd.
$145.00*
На складе

Научная лаборатория по физике, Обучающие ресурсы, набор для изучения науки и другое экспериментальное оборудование для старшей средней школы
- Производитель (Поставщик): Zhejiang Yangguang Education Technology Co., Ltd.
$4.77*
На складе

2025 новые Обучающие ресурсы KRC медицинские эстетические полностью косметические средства для лица, кожный наполнитель, инъекционная Модель со скелетом внутри
- Производитель (Поставщик): Nanjing Kerec Equipment Co., Ltd.
$291.00*
На складе

Другие Обучающие ресурсы, настоящие бабочки, образцы бабочек из смолы в шарах, научные Обучающие наборы
- Производитель (Поставщик): Nanning Benji Biological Technology Co., Ltd.
$8.98*
На складе

Учебные ресурсы для медицинских целей, обучающее оборудование, университетские наборы зоологии, подготовленные слайды с сертификатом CE
- Производитель (Поставщик): Henan Yulin Edu. Project Co., Ltd.
$8.80*
На складе

Высококачественные 100 шт. медицинские паразитологические подготовленные слайды набор биофармацевтические слайды для биологической подготовки
- Производитель (Поставщик): Henan Green Medical Tech Co., Ltd.
$40.17*
На складе

Высокое качество, 100 шт., пластиковая стеклянная анатомическая модель, микробиология, подготовленные Учебные ресурсы для школы, медицинского образования
- Производитель (Поставщик): CENCE MEDIKAL VE TICARET LIMITED SIRKETI
$264.00*
На складе

Эпоксидный кристаллический куб, 4*4*4 см
- Производитель (Поставщик): Nanning Titigood Education Technology Co., Ltd.
$210.00*
На складе